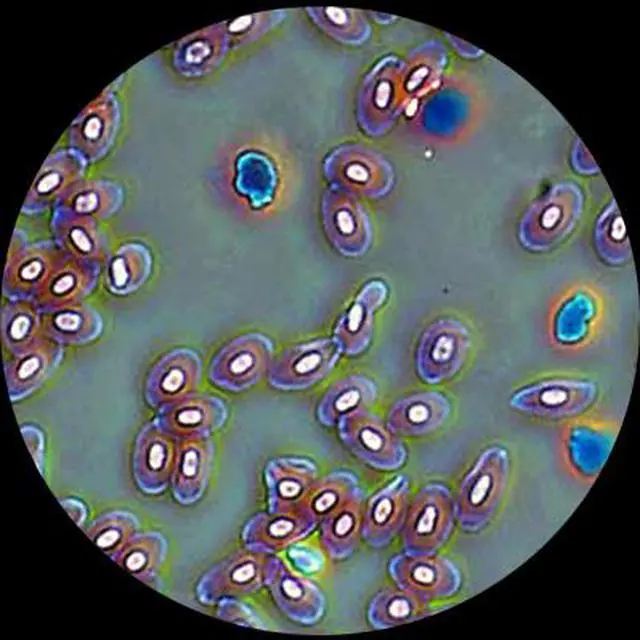
Alt view image 4 of 5 - 40X-1600X Lab Clinic Vet Trinocular Turret Phase Contrast Microscope

Any questions? Our AI beta will help you find out quickly.
This phase contrast microscopy system includes a T490A trinocular microscope and a bright & dark field phase contrast kit. It is a perfect laboratory instrument for clinics, Vets, Doctors, and professional students.
The T490A features a unique "simul-focal" optical system with an adjustable trinocular port to enable well-focused clear images on your PC or video screen while simultaneously obtaining sharp, focused images through the eyepieces. Most trinocular microscopes allow you to view either through the trinocular port or the eyepieces only, forcing you to switch between the two. Since these trinocular ports are not "simul-focal" with the rest of the microscope optical system, you have to re-focus the microscope after each switch. The T490A, however, erases this step by providing "simul-focal" viewing. Especially handy for teaching demonstrations, clinical examinations and laboratory applications, the "simul-focal" feature allows your students or colleagues to view clear images simultaneously while you work through the eyepieces. In addition, the T490A's industry standard 23mm photo port can be converted into a C-Mount port by attaching the included C-mount adapter, allowing you to attach most microscope digital cameras and video systems on the market.
The T490A includes a 30-degree inclined 360-degree swiveling, compensation-free trinocular head, a 3-D mechanical stage, and an intensity-variable halogen illumination system. The bright & dark field phase contrast kit is complete, coming with a phase contrast turret condenser with iris diaphragm, a CT lens, and a set of phase contrast 10x, 20x, 40x and 100x plan objectives. The 1.25NA turret condenser includes open bright field position, DF, and Ph 1, 2, 3, and 4 positions. and retails for more than $3,600.
Features: